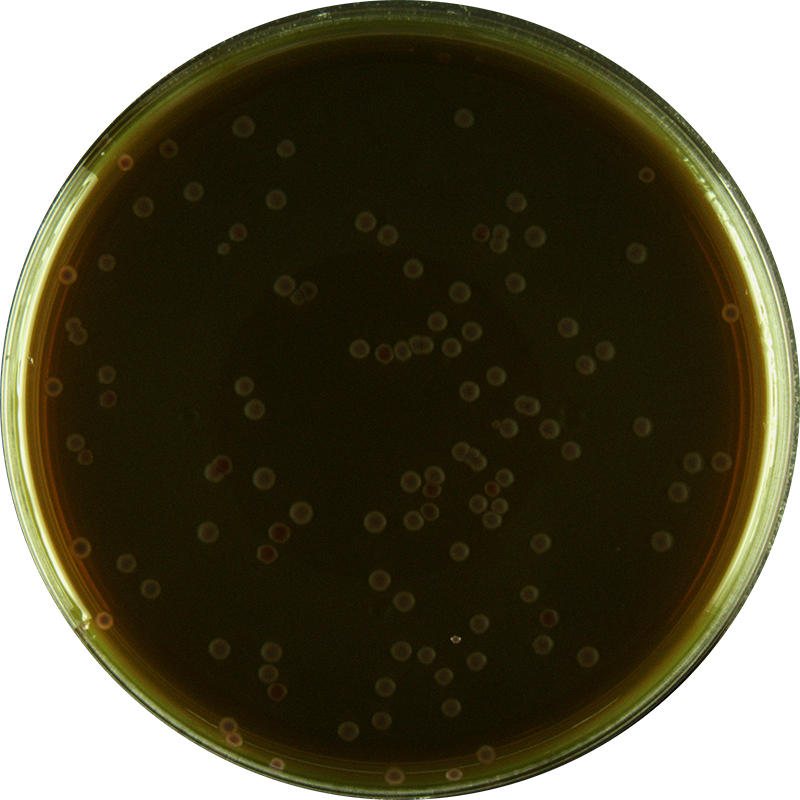

產(chǎn)品中心
曙紅亞甲藍(lán)瓊脂培養(yǎng)基(EMB)
英文名稱(chēng):Eosin-Methylene Blue Agar
貨 號(hào) :K0034
規(guī) 格 :250g
價(jià)格:電詢(xún)
用途:用于微生態(tài)活菌制品微生物限度檢查法中大腸桿菌、大腸菌群和沙門(mén)氏菌的選擇性分離
瀏覽次數(shù):101次
商品詳細(xì)
說(shuō)明書(shū)
產(chǎn)品說(shuō)明更新中!
同名產(chǎn)品
| 產(chǎn)品貨號(hào) | 產(chǎn)品名稱(chēng) | 規(guī)格 | 產(chǎn)品說(shuō)明及用途 |
|---|---|---|---|
| K0034 | 曙紅亞甲藍(lán)瓊脂培養(yǎng)基(EMB) | 250g | 用于微生態(tài)活菌制品微生物限度檢查... |

0513-85596088